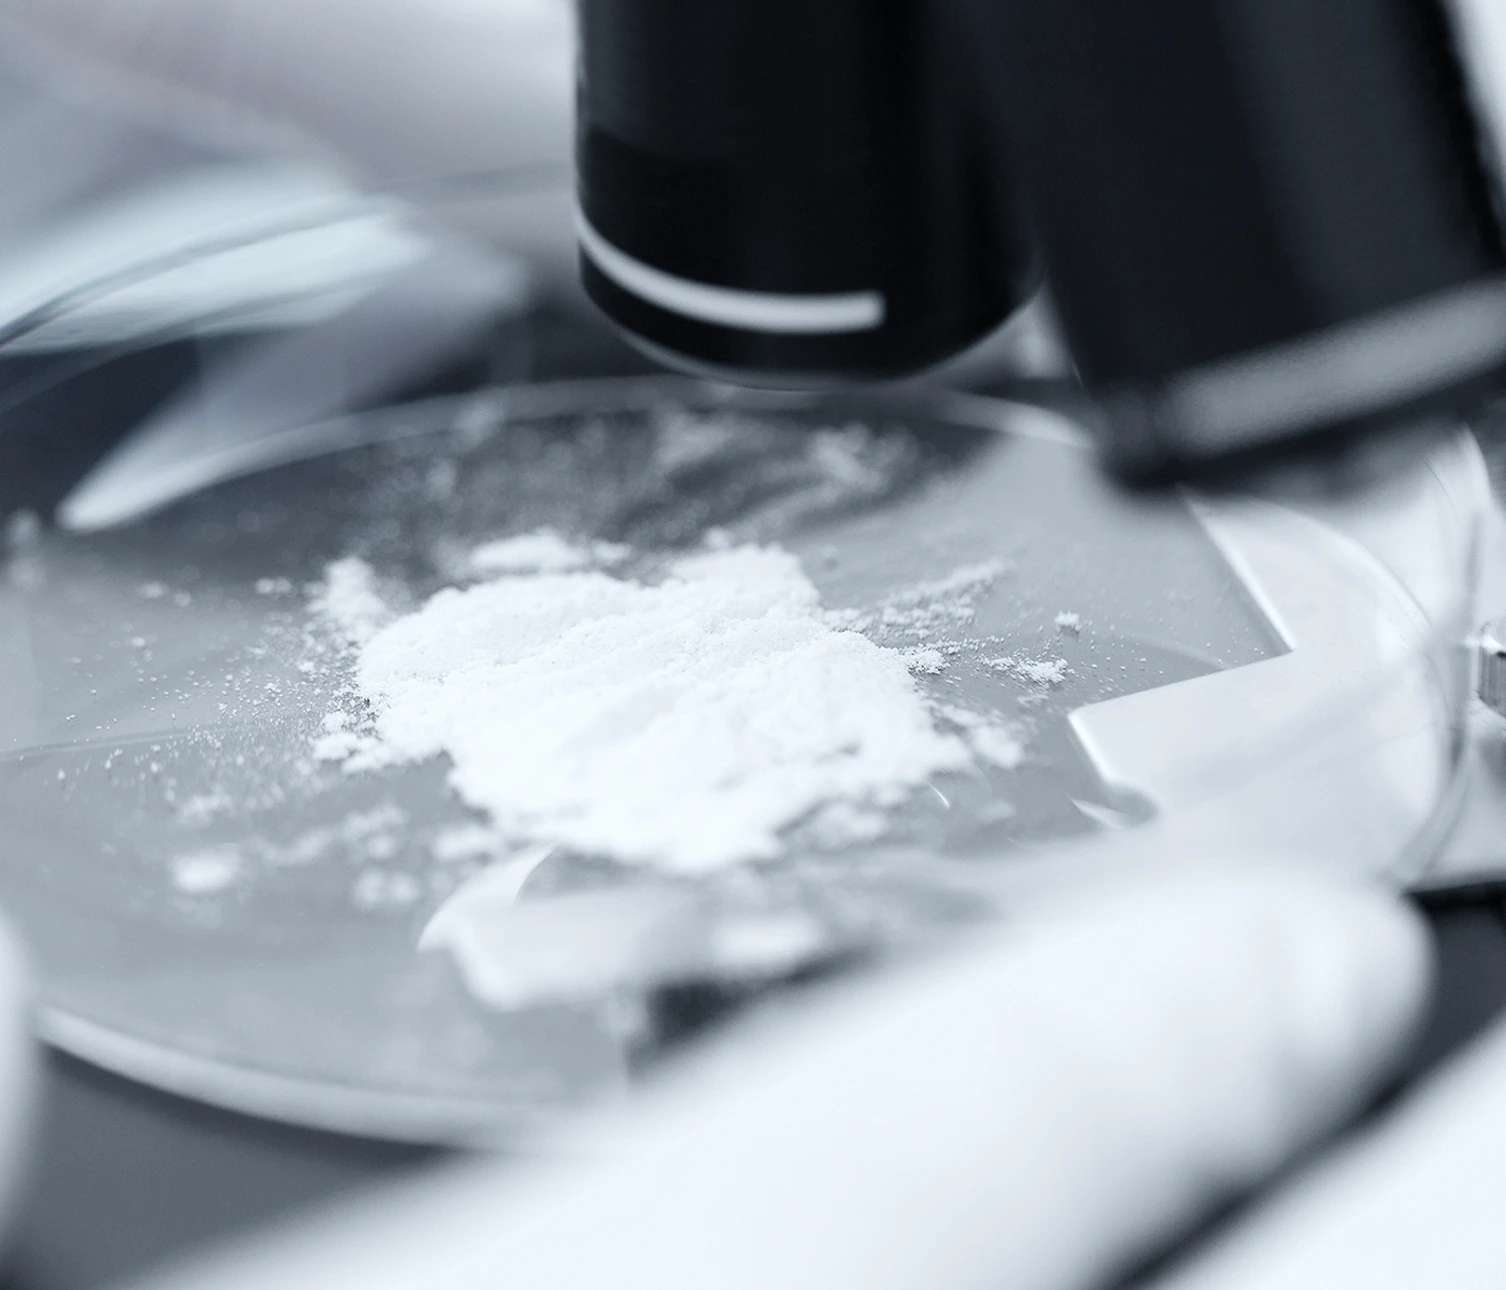

Высокочистый диоксид кремния составляет основу пивного гидрогеля. Материал получают методом контролируемого синтеза, что обеспечивает необходимую чистоту и однородность структуры.
Аморфный диоксид кремния демонстрирует превосходные адсорбционные свойства. Химическая инертность материала исключает нежелательные реакции с компонентами пива. Стабильность структуры сохраняется в широком диапазоне температур и pH.

Аморфный кремнезем демонстрирует превосходные адсорбционные характеристики. Пористая структура материала обеспечивает высокую емкость по адсорбируемым веществам. Объем пор составляет 0,5-1,8 см3/г в зависимости от марки продукта.
Порошок диоксида кремния сохраняет стабильные свойства в процессе эксплуатации. Материал не разрушается под влиянием составляющих пивного сусла. Химическая инертность исключает влияние на органолептические свойства готового продукта.

Процесс белковой стабилизации начинается на молекулярном уровне при контакте гидрогеля с суслом. Нанопористая структура диоксида кремния обеспечивает максимальную площадь контакта с белковыми молекулами. Материал проявляет высокую специфичность к определенным белковым фракциям.
Гидрогель адсорбирует гидрофильные белки с молекулярной массой свыше 40,000 Да. Эти соединения являются основной причиной образования мутности в готовом продукте. Селективность процесса гарантирует сохранение пеногенных свойств пива.

Коллоидное помутнение возникает из-за образования комплексов белок-полифенол в пиве. Эти соединения формируются посредством водородных связей между молекулами. Гидрогель эффективно разрушает такие комплексы на стадии их образования.
Механизм предотвращения помутнения основан на конкурентном связывании белковых молекул. Микропорошок диоксида кремния обладает более высоким сродством к белкам, чем полифенольные соединения. Это обеспечивает стабильность готового продукта при длительном хранении.


Синтетический пивной гидрогель, производимый на заводе, играет роль эффективного стабилизатора в пивоваренной промышленности. Он снижает мутность пива и увеличивает срок его хранения. Технология обеспечивает получение качественного пива с улучшенными характеристиками.
Собственный научно-исследовательский центр "РусСилика" разрабатывает пивные гидрогели с заданными характеристиками специально для пивоваренной промышленности. Исследовательская деятельность направлена на улучшение параметров пористости и адсорбционной активности. Контроль качества осуществляется на всех этапах производства. Лабораторные исследования подтверждают соответствие продукции международным стандартам.
Параметры микронизированного силикагеля RUSGEL в форме гидрогеля для пивоварен включают:
Комплекс данных характеристик позволяет пивному гидрогелю RUSGEL представлять собой высокотехнологичное решение для стабилизации пива. Каждое свойство дополняет остальные, создавая синергетический эффект в технологическом процессе пивного производства.
Пивные гидрогели RUSGEL улучшают традиционные характеристики пива:
Процедура заказа RUSGEL включает несколько этапов:
Компания "РусСилика" предоставляет комплексную техническую поддержку клиентам. Специалисты оказывают помощь во внедрении технологии и оптимизации производственных процессов на пивоварнях любых размеров. Это включает разработку индивидуальных рекомендаций по дозировке и методам введения материала.








© 2020-2024 ООО "РусСилика" ОГРН 1205500027710, ИНН 5501267734, КПП 524901001.
Вся информация на сайте носит справочный характер и не является публичной офертой, определяемой статьей 437 ГК РФ.